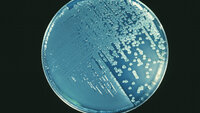
Pseudomonas aeruginosa, petriskål Bildet viser en petriskål med Pseudomonas aeruginosa.

Innlegg av Nina Hernæs som journalist:
Har laget ny retningslinje for Tourettes syndrom
Alle sykepleiere bør kjenne til tics og tourette, mener sykepleier Liv Irene Nøstvik.
Jordmorforbundet: – Dagens abortgrense bør bestå
Men leder Hanne Charlotte Schjelderup er positiv til at det settes ned et utvalg som skal vurdere hvor grensene for selvbestemt abort skal gå.
Kjerkol: Utvalg skal utrede muligheten for utvidet grense for selvbestemt abort
Et regjeringsoppnevnt utvalg skal utrede muligheten for å utvide grensen for selvbestemt abort og skal vurdere et alternativ til dagens abortnemnder.
Vil at alvorlig syke barn skal prioriteres høyere
Barnesykepleiere og barneleger ber politikerne ta grep.
Korona, noro og skabb sto for de fleste smitteutbruddene i 2021
Men ingen har den hele og fulle oversikten over utbrudd av smittsomme sykdommer i Norge.
Astrazeneca beklager etter vaksinebivirkningene
Vaksineprodusenten Astrazeneca beklager at friske, uskyldige mennesker ble rammet av bivirkningen som stanset bruken av denne vaksinen i Norge. Fem mennesker døde.
Hvilke smitteverntiltak er egentlig basale?
Etter to år med forsterkede tiltak, er det på tide å friske opp det basale, mener FHI.
Jakter på håndsydde virus
Smittevern på Oslo universitetssykehus trengte en mer lettbent måte å nå ut på.
Hvordan finne informasjon om legemidler fra Ukraina?
Å finne ut hva et ukrainsk legemiddel tilsvarer under norske forhold kan være utfordrende. Derfor har Relis laget en liten veiviser.
Bakterieutbruddet: Produsent tilbakekaller flere produkter
Det er produkter av merkene Oasis og Conti som nå trekkes tilbake.